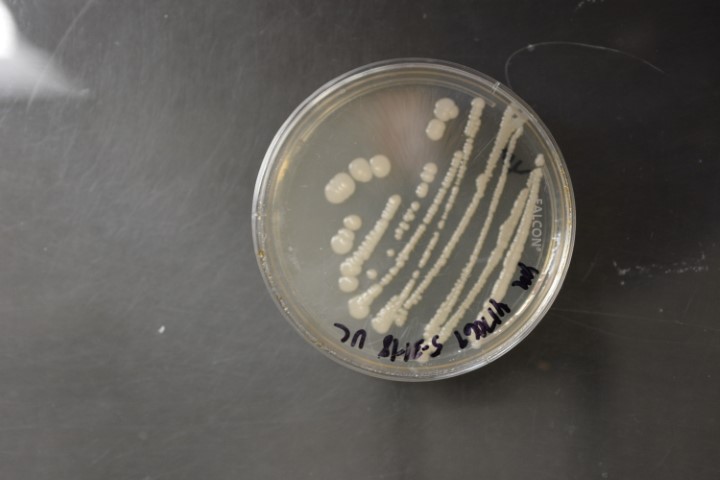

Starmerella bombicola
NRRL Y-17069(Type Strain)
Accession numbers in other collections:ATCC 22214=CBS 6009=CCRC 21323=CCRC 22302=DBVPG 6870=IFO 10243=IFO 1449=JCM 9596=NRIC 1806=PRL 319-67
Source:D.Yarrow,CBS,Delft,The Netherlands
Isolated from(substrate):IN,honey of bumble bee(Bombus sp.)
Genetic info:Robnett PCR#121.GenBank:D1/D2(U45705)(JQ689065),SSU(AB013558)(JQ698924),EF-1 alpha(JQ699088),RPB1(JQ713080),RPB2(JQ699012).
Growth media:Yeast Extract-Malt Extract-Peptone-Glucose(YM for yeasts)(number 6)
Optimum growth temperature:25C
Strain images:
NRRL_Y-17069_6.JPG